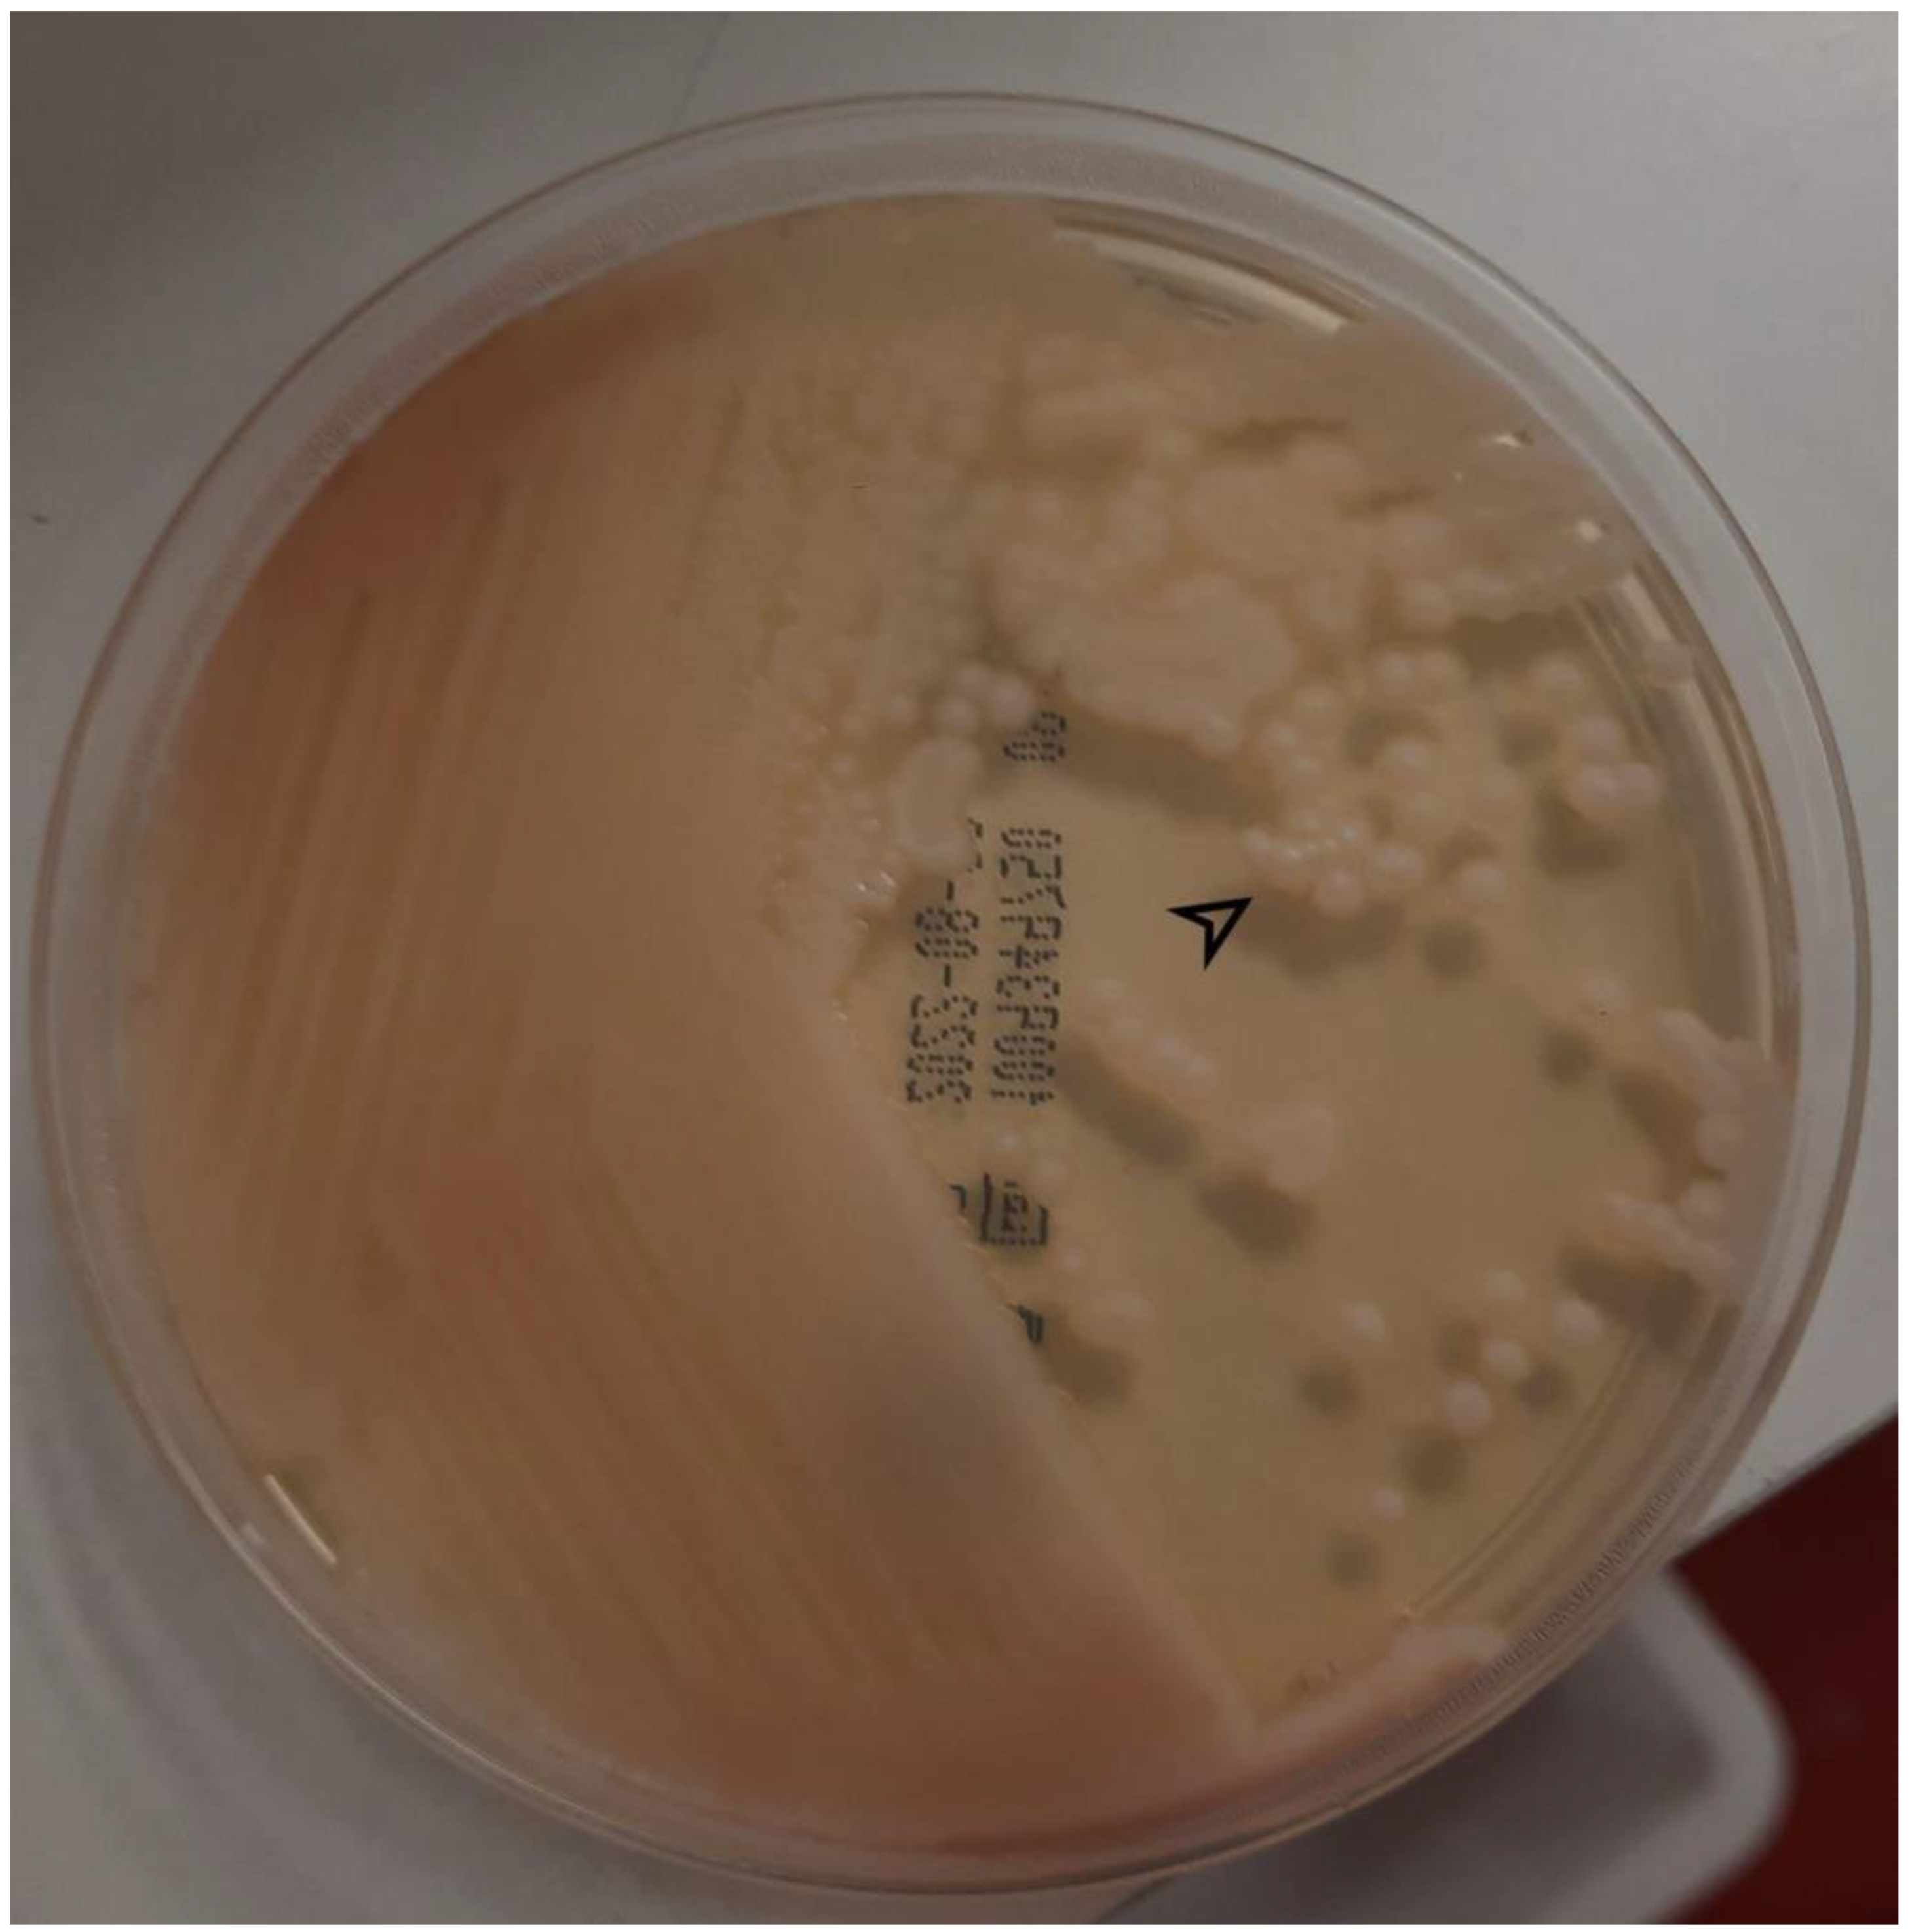
Antibiotics 12 00691 g001

Candida lipolytica Bloodstream Infection in an Adult Patient with COVID-19 and Alcohol Use Disorder: A Unique Case and a Systematic Review of the Literature
Abstract
1. Introduction
2. Materials and Methods
3. Case Presentation
4. Review
5. Discussion
6. Conclusions
Author Contributions
Funding
Institutional Review Board Statement
Informed Consent Statement
Data Availability Statement
Conflicts of Interest
References
- Pappas, P.G.; Kauffman, C.A.; Andes, D.R.; Clancy, C.J.; Marr, K.A.; Ostrosky-Zeichner, L.; Reboli, A.C.; Schuster, M.G.; Vazquez, J.A.; Walsh, T.J.; et al. Clinical Practice Guideline for the Management of Candidiasis: 2016 Update by the Infectious Diseases Society of America. Clin. Infect. Dis. 2016, 62, e1–e50. [Google Scholar] [CrossRef] [PubMed]
- Falagas, M.E.; Roussos, N.; Vardakas, K.Z. Relative Frequency of Albicans and the Various Non-Albicans Candida Spp among Candidemia Isolates from Inpatients in Various Parts of the World: A Systematic Review. Int. J. Infect. Dis. 2010, 14, e954–e966. [Google Scholar] [CrossRef]
- Liu, W.-C.; Chan, M.-C.; Lin, T.-Y.; Hsu, C.-H.; Chiu, S.-K. Candida Lipolytica Candidemia as a Rare Infectious Complication of Acute Pancreatitis: A Case Report and Literature Review. J. Microbiol. Immunol. Infect. 2013, 46, 393–396. [Google Scholar] [CrossRef] [PubMed][Green Version]
- Kim, E.J.; Lee, E.; Kwak, Y.G.; Yoo, H.M.; Choi, J.Y.; Kim, S.R.; Shin, M.J.; Yoo, S.-Y.; Cho, N.-H.; Choi, Y.H. Trends in the Epidemiology of Candidemia in Intensive Care Units from 2006 to 2017: Results from the Korean National Healthcare-Associated Infections Surveillance System. Front. Med. 2020, 7, 606976. [Google Scholar] [CrossRef]
- Machado, M.; Estévez, A.; Sánchez-Carrillo, C.; Guinea, J.; Escribano, P.; Alonso, R.; Valerio, M.; Padilla, B.; Bouza, E.; Muñoz, P. Incidence of Candidemia Is Higher in COVID-19 versus Non-COVID-19 Patients, but Not Driven by Intrahospital Transmission. J. Fungi 2022, 8, 305. [Google Scholar] [CrossRef]
- Wu, X.; Jing, H.; Wang, C.; Wang, Y.; Zuo, N.; Jiang, T.; Novakovic, V.A.; Shi, J. Intestinal Damage in COVID-19: SARS-CoV-2 Infection and Intestinal Thrombosis. Front. Microbiol. 2022, 13, 860931. [Google Scholar] [CrossRef]
- Zhao, Y.; Chan, J.F.-W.; Tsang, C.-C.; Wang, H.; Guo, D.; Pan, Y.; Xiao, Y.; Yue, N.; Chen, J.H.-K.; Lau, S.K.-P.; et al. Clinical Characteristics, Laboratory Identification, and In Vitro Antifungal Susceptibility of Yarrowia (Candida) Lipolytica Isolates Causing Fungemia: A Multicenter, Prospective Surveillance Study. J. Clin. Microbiol. 2015, 53, 3639–3645. [Google Scholar] [CrossRef] [PubMed]
- Wehrspann, P.; Füllbrandt, U. Report of a case of Yarrowia lipolytica (Wickerman et al.) van der Walt & von Arx isolated from a blood culture. Mykosen 1985, 28, 217–222. [Google Scholar] [PubMed]
- Moher, D.; Liberati, A.; Tetzlaff, J.; Altman, D.G. The PRISMA Group Preferred Reporting Items for Systematic Reviews and Meta-Analyses: The PRISMA Statement. PLoS Med. 2009, 6, e1000097. [Google Scholar] [CrossRef] [PubMed]
- Martínez, E.M.M.; Marín Martínez, E.M.; García, A.I.A.; Martín-Mazuelos, E. Epidemiología, Factores de Riesgo Y Sensibilidad in Vitro En Candidemias Por Especies Diferentes de Candida Albicans. Rev. Iberoam. Micol. 2016, 33, 248–252. [Google Scholar] [CrossRef]
- Blanco, M.T.; García-Martos, P.; García-Tapia, A.; Fernández, C.; Navarro, J.; Guerrero, F. Fungemia Por Candida Lipolytica: A Propósito de 2 Casos. Rev. Iberoam. Micol. 2009, 26, 211–212. [Google Scholar] [CrossRef]
- Belet, N.; Ciftçi, E.; Ince, E.; Dalgiç, N.; Oncel, S.; Güriz, H.; Yagmurlu, A.; Dindar, H.; Doğru, U. Caspofungin Treatment in Two Infants with Persistent Fungaemia due to Candida Lipolytica. Scand. J. Infect. Dis. 2006, 38, 559–562. [Google Scholar] [CrossRef] [PubMed]
- Chi, H.-Y.; Su, Y.-S.; Chen, F.-L.; Lee, W.-S.; Wang, C.-H. Breakthrough Fungemia Caused by Yarrowia Lipolytica in a Patient with Gastric Adenocarcinoma during Echinocandin Therapy. J. Infect. 2021, 82, e52–e53. [Google Scholar] [CrossRef]
- Ye, Q.; Xu, X.; Li, J.; Cao, H. Fungemia Caused by Yarrowia Lipolytica in a Patient with Acute Lymphoblastic Leukemia. J. Pediatr. Hematol. Oncol. 2011, 33, e120–e121. [Google Scholar] [CrossRef] [PubMed]
- D’Antonio, D.; Romano, F.; Pontieri, E.; Fioritoni, G.; Caracciolo, C.; Bianchini, S.; Olioso, P.; Staniscia, T.; Sferra, R.; Boccia, S.; et al. Catheter-Related Candidemia Caused by Candida Lipolytica in a Patient Receiving Allogeneic Bone Marrow Transplantation. J. Clin. Microbiol. 2002, 40, 1381–1386. [Google Scholar] [CrossRef]
- Chang, C.L.; Park, T.H.; Lee, E.Y.; Lim, Y.T.; Son, H.C. Recurrent Self-Limited Fungemia Caused by Yarrowia Lipolytica in a Patient with Acute Myelogenous Leukemia. J. Clin. Microbiol. 2001, 39, 1200–1201. [Google Scholar] [CrossRef] [PubMed][Green Version]
- Agarwal, S.; Thakur, K.; Kanga, A.; Singh, G.; Gupta, P. Catheter-Related Candidemia Caused by Candida Lipolytica in a Child with Tubercular Meningitis. Indian J. Pathol. Microbiol. 2008, 51, 298. [Google Scholar] [CrossRef] [PubMed]
- Ozdemir, H.; Karbuz, A.; Ciftçi, E.; Dinçaslan, H.U.; Ince, E.; Aysev, D.; Yavuz, G.; Doğru, U. Successful Treatment of Central Venous Catheter Infection due to Candida Lipolytica by Caspofungin-Lock Therapy. Mycoses 2011, 54, e647–e649. [Google Scholar] [CrossRef]
- Lai, C.-C.; Lee, M.-R.; Hsiao, C.-H.; Tan, C.-K.; Lin, S.-H.; Liao, C.-H.; Huang, Y.-T.; Hsueh, P.-R. Infections Caused by Candida Lipolytica. J. Infect. 2012, 65, 372–374. [Google Scholar] [CrossRef] [PubMed]
- Shin, J.H.; Kook, H.; Shin, D.H.; Hwang, T.J.; Kim, M.; Suh, S.P.; Ryang, D.W. Nosocomial Cluster of Candida Lipolytica Fungemia in Pediatric Patients. Eur. J. Clin. Microbiol. Infect. Dis. 2000, 19, 344–349. [Google Scholar] [CrossRef]
- Taj-Aldeen, S.J.; AbdulWahab, A.; Kolecka, A.; Deshmukh, A.; Meis, J.F.; Boekhout, T. Uncommon Opportunistic Yeast Bloodstream Infections from Qatar. Med. Mycol. 2014, 52, 552–556. [Google Scholar] [CrossRef]
- Walsh, T.J.; Salkin, I.F.; Dixon, D.M.; Hurd, N.J. Clinical, Microbiological, and Experimental Animal Studies of Candida Lipolytica. J. Clin. Microbiol. 1989, 27, 927–931. [Google Scholar] [CrossRef]
- Trabelsi, H.; Chtara, K.; Khemakhem, N.; Néji, S.; Cheikhrouhou, F.; Sellami, H.; Guidara, R.; Makni, F.; Bouaziz, M.; Ayadi, A. Fungemia Caused by Yarrowia Lipolytica. Mycopathologia 2015, 179, 437–445. [Google Scholar] [CrossRef]
- Abbes, S.; Amouri, I.; Trabelsi, H.; Neji, S.; Sellami, H.; Rahmouni, F.; Makni, F.; Rebai, T.; Ayadi, A. Analysis of Virulence Factors And in Vivo biofilm-Forming Capacity of Yarrowia Lipolytica isolated from Patients with Fungemia. Med. Mycol. 2017, 55, 193–202. [Google Scholar] [CrossRef] [PubMed]
- Gao, W.; Zhu, Y.; Ye, J.; Chu, H. Gut Non-Bacterial Microbiota Contributing to Alcohol-Associated Liver Disease. Gut Microbes 2021, 13, 1984122. [Google Scholar] [CrossRef]
- Seelbinder, B.; Chen, J.; Brunke, S.; Vazquez-Uribe, R.; Santhaman, R.; Meyer, A.-C.; de Oliveira Lino, F.S.; Chan, K.-F.; Loos, D.; Imamovic, L.; et al. Antibiotics Create a Shift from Mutualism to Competition in Human Gut Communities with a Longer-Lasting Impact on Fungi than Bacteria. Microbiome 2020, 8, 133. [Google Scholar] [CrossRef]
- Jensen, J.-U.S.; Hein, L.; Lundgren, B.; Bestle, M.H.; Mohr, T.; Andersen, M.H.; Løken, J.; Tousi, H.; Søe-Jensen, P.; Lauritsen, A.Ø.; et al. Invasive Candida Infections and the Harm from Antibacterial Drugs in Critically Ill Patients: Data from a Randomized, Controlled Trial to Determine the Role of Ciprofloxacin, Piperacillin-Tazobactam, Meropenem, and Cefuroxime. Crit. Care Med. 2015, 43, 594–602. [Google Scholar] [CrossRef]
- Chiurlo, M.; Mastrangelo, A.; Ripa, M.; Scarpellini, P. Invasive Fungal Infections in Patients with COVID-19: A Review on Pathogenesis, Epidemiology, Clinical Features, Treatment, and Outcomes. New Microbiol. 2021, 44, 71–83. [Google Scholar] [PubMed]
- Zuo, T.; Zhan, H.; Zhang, F.; Liu, Q.; Tso, E.Y.K.; Lui, G.C.Y.; Chen, N.; Li, A.; Lu, W.; Chan, F.K.L.; et al. Alterations in Fecal Fungal Microbiome of Patients with COVID-19 during Time of Hospitalization until Discharge. Gastroenterology 2020, 159, 1302–1310.e5. [Google Scholar] [CrossRef] [PubMed]
- Fioriti, S.; Brescini, L.; Pallotta, F.; Canovari, B.; Morroni, G.; Barchiesi, F. Antifungal Combinations against Candida Species: From Bench to Bedside. J. Fungi 2022, 8, 1077. [Google Scholar] [CrossRef] [PubMed]

| Author/ Year | Country | Age^ Gender | Catheter-Related | Immunocompromising Underlying Disease | PN | Recent Abdominal Surgery * | Underlying Diseases | Source Control (Y/N) | Septic Shock (Y/N) | Treatment (Drug and Duration) | Complications (Persistence, Recurrence, Other) | Coinfections | Outcome | Ref. |
|---|---|---|---|---|---|---|---|---|---|---|---|---|---|---|
| Marín Martínez, 2016 | Spain | 86 F | Y | N | N | Y | DM | NR | N | NR | N | N | NR | [10] |
| Blanco, 2009 | Spain | 12 F | Y | Y (pancreatic fibrosis) | Y | N | Cystic pancreatic fibrosis | Y | N | Voriconazole (MIC 0.06 mg/L) | N | Pneumonia | Resolution | [11] |
| Blanco, 2009 | Spain | 86 F | Y | Y (bladder cancer) | N | N | Hypertension; DM; dementia; UTI | Y | N | Caspofungin (MIC 0.5 mg/L) | N | N | Resolution | [11] |
| Belet, 2015 | Turkey | 2 days, M | Y | N | Y | Y | Intestinal obstruction | Y | N | AMB (24 d) + caspofungin (10 d) | Persistence | N | Resolution | [12] |
| Belet, 2015 | Turkey | 4 months, F | Y | N | Y | N | Gastroesophageal reflux | Y | N | Amphotericin B + caspofungin | Persistence | MRSA pneumonia | Resolution | [12] |
| Chi, 2017 | Taiwan | 44 M | Y | Y (gastric cancer) | N | Y | Gastric cancer | N | Y | Voriconazole (MIC 0.06 μg/mL) | N | A. baumannii BSI, C. tropicalis BSI (in therapy) | Death | [13] |
| Ye, 2011 | China | 13 M | Y | Y (ALL) | N | N | ALL | Y | N | Fluco | N | N | Resolution | [14] |
| D’Antonio, 2002 | Italy | 18 F | Y | Y (allogeneic BMT) | N | N | ALL | Y | N | AMB (1st episode: 10 d, MIC 0.39 μg/mL) | Recurrence | CMV pneumonia | Death | [15] |
| Chang, 2001 | Korea | 15 F | Y | Y (AML) | N | N | AML | Y | N | None | Recurrence | S. malthophilia BSI | Resolution | [16] |
| Agarwal, 2008 | India | 2 M | Y | N | N | N | N | Y | N | AMB (2nd episode) | Recurrence | TB meningitis | Resolution | [17] |
| Ozdemir, 2011 | Turkey | 9 M | Y | Y (neuroblastoma) | Y | N | Relapsed neuroblastoma | N | N | Caspofungin (14 d after fungemia clearance) + lock | N | N | Resolution | [18] |
| Lai, 2012 | Taiwan | 61 M | Y | Y (lung cancer) | N | N | Lung cancer | Y | Y | Fluco (MIC 1 μg/mL), then micafungin | Persistence | C. albicans BSI, pneumonia | Resolution | [19] |
| Shin, 2000 | Korea | 1 month, M | Y | N | Y | N | Necrotisingenterocolitis | Y | N | Fluco (6 d, MIC 32 μg/mL) | Persistence | N | Resolution | [20] |
| Shin, 2000 | Korea | 2 month, M | N | N | N | N | N | N | N | None | N | Streptococcal meningitis | Resolution | [20] |
| Shin, 2000 | Korea | 8 F | Y | Y (AML) | N | N | AML | N | N | AMB (6 d, MIC 0.5 μg/mL) | Persistence | N | Resolution | [20] |
| Shin, 2000 | Korea | 14 M | Y | Y (AML) | Y | N | AML | N | N | AMB (21 d, MIC 0.5 μg/mL) | Persistence | N | Resolution | [20] |
| Shin, 2000 | Korea | 4 M | Y | Y (aplastic anaemia) | N | N | Aplastic anaemia | Y | N | Fluco (MIC 32 μg/mL) | Persistence | N | Resolution | [20] |
| Taj-Aldeen, 2014 | Qatar | 77 F | NR | N | N | N | DM, renal failure | NR | NR | Caspofungin (MIC 2 μg/mL) | NR | NR | Death | [21] |
| Walsh, 1989 | USA | 54 M | Y | N | N | Y | Alcohol abuse, cholelithiasis | Y | N | None | Catheter-related thrombophlebitis, persistence | N | Resolution | [22] |
| Wehrspann, 1984 | Germany | 57 F | Y | Y | N | N | Alcohol abuse, stroke, peptic ulcer | Y | N | Ketoconazole | N | Infective endocarditis | Resolution | [8] |
| Liu, 2013 | Taiwan | 84 M | N | N | N | N | Acute pancreatitis | N | N | Fluco (MIC 1 μg/mL), then micafungin (total 14 d) | Persistence | N | Resolution | [3] |
| Zhao, 2015 | China | 65 M | Y | N | NR | Y | Polytrauma with subdural haematoma | Y | NR | Fluco (MIC 4 μg/mL) | N | N | Resolution | [7] |
| Zhao, 2015 | China | 46 M | Y | N | NR | N | Rheumatic heart disease | Y | NR | None | N | N | Resolution | [7] |
| Zhao, 2015 | China | 27 M | Y | N | NR | N | Cervical spinal fracture, paraplegia | Y | NR | None | N | N | Resolution | [7] |
| Zhao, 2015 | China | 67 M | Y | N | NR | N | Stroke | Y | NR | Itraconazole (MIC 0.5 μg/mL) | N | N | Resolution | [7] |
| Zhao, 2015 | China | 73 M | Y | Y (pancreatic cancer) | NR | N | Pancreatic cancer | Y | NR | AMB (MIC 0.5 μg/mL) | N | Recurrent peritonitis | Resolution | [7] |
| Zhao, 2015 | China | 1 M | Y | N | NR | N | Prematurity | Y | NR | None | N | N | Resolution | [7] |
| Zhao, 2015 | China | 3 M | Y | N | NR | N | Congenital heart disease | Y | NR | Fluco (MIC 16 μg/mL) | N | N | Resolution | [7] |
| Zhao, 2015 | China | 63 M | Y | N | NR | N | Bronchiectasis | Y | NR | Fluco (MIC > 256 μg/mL) | N | N | Death | [7] |
| Zhao, 2015 | China | 75 M | Y | N | NR | N | Cerebral haemorrhage | Y | NR | Fluco (MIC 64 μg/mL) | N | N | Death | [7] |
| Zhao, 2015 | China | 43 M | Y | N | NR | N | Brainstem death | Y | NR | None | N | Pneumonia | Resolution | [7] |
| Zhao, 2015 | China | 45 M | Y | N | NR | Y | N | Y | NR | Fluco (MIC 128 μg/mL) | N | N | Resolution | [7] |
| Zhao, 2015 | China | 73 M | Y | N | NR | N | N | Y | NR | Fluco (MIC 64 μg/mL) | N | N | Resolution | [7] |
| Zhao, 2015 | China | 82 F | Y | N | NR | N | N | Y | NR | Fluco (MIC 64 μg/mL) | N | N | Death | [7] |
| Trabelsi **, 2015 | Tunisia | 21 M | Y | N | Y | Y | Polytraumatism | Y | N | AMB (13 d) + Fluco (17 d) | N | N | Resolution | [23] |
| Trabelsi, 2015 | Tunisia | 39 M | Y | N | N | N | Polytraumatism | Y | N | None | N | N | Resolution | [23] |
| Trabelsi, 2015 | Tunisia | 60 F | Y | N | Y | N | DM, stroke | Y | Y | Fluco (3 d) + AMB (6 d) | N | Pneumonia | Death | [23] |
| Trabelsi, 2015 | Tunisia | 48 F | Y | N | N | N | Polytraumatism | Y | N | Fluco (7 d) | N | Pneumonia | Resolution | [23] |
| Trabelsi, 2015 | Tunisia | 32 F | Y | N | N | N | DM | N | N | Fluco (3 d) + AMB (1 d) | N | N | Death | [23] |
| Trabelsi, 2015 | Tunisia | 15 F | Y | N | N | Y | Acute anaemia | Y | N | Fluco (9 d) | N | N | Death | [23] |
| Trabelsi, 2015 | Tunisia | 78 M | Y | N | N | N | COPD | N | N | Fluco (7 d) | N | N | Resolution | [23] |
| Trabelsi, 2015 | Tunisia | 50 M | Y | Y (colon cancer) | Y | Y | Colon cancer | N | N | Fluco (6 d) + AMB (17 d) | N | Peritonitis | Death | [23] |
| Trabelsi, 2015 | Tunisia | 60 M | Y | N | N | N | CKD, DM | N | Y | AMB (2 d) | N | N | Death | [23] |
| Trabelsi, 2015 | Tunisia | 47 M | Y | N | N | Y | Polytraumatism | Y | N | AMB (10 d) | N | Pneumonia | Resolution | [23] |
| Trabelsi, 2015 | Tunisia | 27 M | Y | N | N | Y | Thoracic traumatism | Y | N | Fluco (23 d) | N | N | Resolution | [23] |
| Trabelsi, 2015 | Tunisia | 43 M | Y | N | N | N | Polytraumatism | Y | N | Fluco | N | N | Resolution | [23] |
| Trabelsi, 2015 | Tunisia | 52 M | Y | N | N | N | Renal failure, stroke | Y | N | Fluco (2 d) + AMB (7 d) | N | Pneumonia | Death | [23] |
| Trabelsi, 2015 | Tunisia | 68 M | N | N | N | N | COPD | N | N | Fluco | N | N | Resolution | [23] |
| Trabelsi, 2015 | Tunisia | 36 M | Y | N | Y | Y | Polytraumatism | Y | N | Fluco + AMB | N | N | Death | [23] |
| Trabelsi, 2015 | Tunisia | 18 M | Y | N | N | N | Polytraumatism | Y | N | AMB (8 d) | N | N | Resolution | [23] |
| Trabelsi, 2015 | Tunisia | 51 M | Y | N | N | N | Polytraumatism | Y | Y | Fluco (14 d) + AMB (6 d) | N | N | Resolution | [23] |
| Trabelsi, 2015 | Tunisia | 46 M | Y | N | Y | Y | Polytraumatism | Y | N | AMB (14 d) | N | Pneumonia | Resolution | [23] |
| Trabelsi, 2015 | Tunisia | 62 F | Y | N | Y | N | Acute pancreatitis | N | Y | AMB (2 d) | N | N | Death | [23] |
| Trabelsi, 2015 | Tunisia | 20 M | Y | N | Y | N | Polytraumatism | Y | N | Fluco (25 d) | N | N | Death | [23] |
| Trabelsi, 2015 | Tunisia | 73 M | Y | N | N | N | Renal failure, DM, myocardial infarction | Y | Y | None | N | N | Death | [23] |
| Trabelsi, 2015 | Tunisia | 74 M | Y | N | N | N | DM, polytraumatism | Y | Y | Fluco (13 d) + AMB (2 d) | N | N | Death | [23] |
| Trabelsi, 2015 | Tunisia | 14 F | Y | N | Y | N | Status epilepticus | Y | N | Fluco (16 d) | N | N | Resolution | [23] |
| Trabelsi, 2015 | Tunisia | 57 M | Y | N | N | N | DM, polytraumatism | Y | N | None | N | N | Death | [23] |
| Trabelsi, 2015 | Tunisia | 35 F | Y | N | N | Y | Post-operative shock | Y | N | Fluco | N | N | Resolution | [23] |
| Trabelsi, 2015 | Tunisia | 16 M | Y | N | N | Y | Polytraumatism | Y | N | Fluco (11 d) + AMB (16 d) | N | N | Resolution | [23] |
| Trabelsi, 2015 | Tunisia | 58 F | Y | N | Y | Y | Heart failure, DM | Y | N | Fluco + AMB | N | N | Death | [23] |
| Trabelsi, 2015 | Tunisia | 50 M | Y | N | Y | N | Guillain Barrè, COPD | Y | Y | None | N | N | Death | [23] |
| Trabelsi, 2015 | Tunisia | 36 F | Y | N | N | N | Polytraumatism | N | N | AMB | N | N | Resolution | [23] |
| Trabelsi, 2015 | Tunisia | 45 F | Y | N | Y | N | N | Y | N | AMB (6 d) | N | Pneumonia | Death | [23] |
| Trabelsi, 2015 | Tunisia | 21 M | Y | N | N | N | Polytraumatism | N | N | AMB | N | N | Resolution | [23] |
| Trabelsi, 2015 | Tunisia | 61 M | Y | N | Y | N | Polytraumatism | Y | N | AMB | N | N | Resolution | [23] |
| Trabelsi, 2015 | Tunisia | 26 M | Y | N | N | N | Polytraumatism | Y | N | None | N | N | Resolution | [23] |
| Trabelsi, 2015 | Tunisia | 78 M | Y | N | N | Y | Polytraumatism | N | Y | None | Splenic infarct | N | Death | [23] |
| Trabelsi, 2015 | Tunisia | 27 M | Y | N | N | N | Polytraumatism | Y | N | AMB (14 d) | N | N | Resolution | [23] |
| Trabelsi, 2015 | Tunisia | 83 M | Y | N | Y | N | Heart failure, trauma | N | N | None | N | N | Death | [23] |
| Trabelsi, 2015 | Tunisia | 42 M | Y | N | N | N | DM, polytraumatism, pneumothorax | Y | N | AMB | N | Pneumonia | Resolution | [23] |
| Trabelsi, 2015 | Tunisia | 30 M | Y | N | Y | N | DM, polytraumatism | Y | N | None | N | N | Resolution | [23] |
| Trabelsi, 2015 | Tunisia | 45 M | Y | N | N | N | DM, polytraumatism | N | N | AMB + fluco | N | Pneumonia | Death | [23] |
| Trabelsi, 2015 | Tunisia | 50 M | N | Y (pharyngeal cancer) | N | N | Pharyngeal cancer | N | N | AMB (2 d) | N | N | Death | [23] |
| Trabelsi, 2015 | Tunisia | 61 M | Y | N | Y | Y | DM, colitis | N | Y | Fluco (7 d) | N | N | Resolution | [23] |
| Trabelsi, 2015 | Tunisia | 52 M | Y | N | Y | Y | Rectocolitis | N | N | AMB (1 d) | Thrombophlebitis | N | Death | [23] |
| Trabelsi, 2015 | Tunisia | 36 F | Y | N | N | N | DM, CKD | Y | Y | None | N | N | Resolution | [23] |
| Trabelsi, 2015 | Tunisia | 25 F | Y | N | Y | N | DM, epilepsy, caustic oesophagitis | Y | N | AMB (4 d) | N | Pneumonia | Death | [23] |
| Trabelsi, 2015 | Tunisia | 38 M | Y | N | Y | N | Polytraumatism, DM | Y | N | AMB | N | N | Death | [23] |
| Trabelsi, 2015 | Tunisia | 29 M | Y | N | Y | Y | Abdominal trauma | N | Y | AMB + fluco | N | Pneumonia | Death | [23] |
| Trabelsi, 2015 | Tunisia | 30 M | Y | N | N | N | Thoracic trauma | Y | N | None | N | Lung abscess | Death | [23] |
| Trabelsi, 2015 | Tunisia | 46 M | Y | N | N | N | DM, COPD | N | Y | Fluco | N | N | Death | [23] |
| Trabelsi, 2015 | Tunisia | 32 M | Y | N | N | N | N | Y | Y | AMB | N | Pneumonia | NR | [23] |
| Trabelsi, 2015 | Tunisia | 34 M | Y | N | N | N | Polytraumatism | N | N | Fluco | N | N | Resolution | [23] |
| Trabelsi, 2015 | Tunisia | 64 M | Y | N | N | N | Haemorrhagic stroke | Y | N | AMB + fluco | N | Pneumonia | Death | [23] |
| Trabelsi, 2015 | Tunisia | 60 M | Y | N | N | N | DM, pulmonary oedema | Y | N | Fluco | N | N | Resolution | [23] |
| Trabelsi, 2015 | Tunisia | 4 M | Y | N | N | N | Caustic oesophagitis | Y | Y | None | N | N | Death | [23] |
| Trabelsi, 2015 | Tunisia | 40 M | Y | N | N | N | Polytraumatism | Y | N | None | N | N | Death | [23] |
| Trabelsi, 2015 | Tunisia | 18 M | Y | N | N | N | Polytraumatism | Y | N | AMB | N | Pneumonia | Resolution | [23] |
Disclaimer/Publisher’s Note: The statements, opinions and data contained in all publications are solely those of the individual author(s) and contributor(s) and not of MDPI and/or the editor(s). MDPI and/or the editor(s) disclaim responsibility for any injury to people or property resulting from any ideas, methods, instructions or products referred to in the content. |
© 2023 by the authors. Licensee MDPI, Basel, Switzerland. This article is an open access article distributed under the terms and conditions of the Creative Commons Attribution (CC BY) license (https://creativecommons.org/licenses/by/4.0/).
Share and Cite
Simonetti, O.; Zerbato, V.; Sincovich, S.; Cosimi, L.; Zorat, F.; Costantino, V.; Di Santolo, M.; Busetti, M.; Di Bella, S.; Principe, L.; et al. Candida lipolytica Bloodstream Infection in an Adult Patient with COVID-19 and Alcohol Use Disorder: A Unique Case and a Systematic Review of the Literature. Antibiotics 2023, 12, 691. https://doi.org/10.3390/antibiotics12040691
Simonetti O, Zerbato V, Sincovich S, Cosimi L, Zorat F, Costantino V, Di Santolo M, Busetti M, Di Bella S, Principe L, et al. Candida lipolytica Bloodstream Infection in an Adult Patient with COVID-19 and Alcohol Use Disorder: A Unique Case and a Systematic Review of the Literature. Antibiotics. 2023; 12(4):691. https://doi.org/10.3390/antibiotics12040691
Chicago/Turabian StyleSimonetti, Omar, Verena Zerbato, Sara Sincovich, Lavinia Cosimi, Francesca Zorat, Venera Costantino, Manuela Di Santolo, Marina Busetti, Stefano Di Bella, Luigi Principe, and et al. 2023. "Candida lipolytica Bloodstream Infection in an Adult Patient with COVID-19 and Alcohol Use Disorder: A Unique Case and a Systematic Review of the Literature" Antibiotics 12, no. 4: 691. https://doi.org/10.3390/antibiotics12040691
APA StyleSimonetti, O., Zerbato, V., Sincovich, S., Cosimi, L., Zorat, F., Costantino, V., Di Santolo, M., Busetti, M., Di Bella, S., Principe, L., & Luzzati, R. (2023). Candida lipolytica Bloodstream Infection in an Adult Patient with COVID-19 and Alcohol Use Disorder: A Unique Case and a Systematic Review of the Literature. Antibiotics, 12(4), 691. https://doi.org/10.3390/antibiotics12040691

